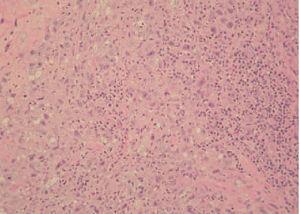

INTRODUCCIÓN
La enfermedad de Hodgkin es una neoplasia maligna que se desarrolla primariamente en los órganos linfáticos. La afectación cutánea ocurre entre el 13 y el 53 % de los casos. La mayoría de estos pacientes presenta una afectación cutánea inespecífica en forma de ictiosis, prurito, hiperpigmentación, urticaria, eritrodermia, dermatitis exfoliativa, eritema multiforme, eritema nudoso, erupciones psoriasiformes y herpes zóster 1-3 . La afectación cutánea específica por enfermedad de Hodgkin es mucho menos frecuente, y sucede entre el 0,5 y el 7,5 % de los pacientes 3,4 . Esta afectación específica suele ocurrir en pacientes en estadios avanzados de la enfermedad y supone un empeoramiento del pronóstico. También se han descrito casos donde la afectación cutánea supone la primera manifestación de la enfermedad de Hodgkin 5 . El diagnóstico histológico de enfermedad de Hodgkin en la piel no es sencillo, puesto que el infiltrado tu-moral puede ser idéntico al de otras enfermedades, entre ellas los procesos linfoproliferativos o las metástasis cutáneas. Por lo tanto, se precisan técnicas inmunohistoquímicas mediante las cuales se pueda establecer el diagnóstico definitivo.
Aportamos el caso de una mujer de 73 años previamente diagnosticada de enfermedad de Hodgkin tipo depleción linfocitaria en estadio IV, que desarrolló varias placas subcutáneas, muy infiltradas a la palpación, en la región lumbosacra y en quién una biopsia confirmó la afectación cutánea específica por su enfermedad.
DESCRIPCIÓN DEL CASO
Una mujer de 73 años, diagnosticada de enfermedad de Hodgkin en estadio IV-E, de tipo depleción linfocitaria, presentaba una lesión osteolítica en el ala sacra izquierda que englobaba partes blandas y raíces nerviosas y otra masa en la quinta vértebra lumbar. La paciente consultó por la presencia, en la misma región lumbosacra izquierda, de unas placas eritematosas, de 1-2 cm de diámetro, muy infiltradas a la palpación y de tiempo de evolución indeterminado (fig. 1). Se practicó una biopsia cutánea, en la que se pudo observar un infiltrado tumoral que afectaba a la dermis profunda y al tejido celular subcutáneo, respetando la dermis superficial y la epidermis. La neoplasia estaba constituida por abundantes células mononucleadas atípicas (células de Hodgkin) y por células multinucleadas correspondientes a células de Reed-Sternberg (fig. 2), acompañadas por un escaso infiltrado de células inflamatorias no neoplásicas compuesto por linfocitos, eosinófilos e histiocitos predominantemente, en una estroma desmoplásica (fig. 3). Las células neoplásicas fueron positivas para CD30, CD15 y aisladas células se tiñeron con antígeno de membrana epitelial (EMA). No se obtuvo inmunotinción positiva para el antígeno leucocitario común (CD45), para marcadores B (CD20 y CD79a), marcadores T (CD3, CD43, CD4 y CD8), ni para el resto de anticuerpos monoclonales empleados (creatincinasa, HMB-45, CD68, CD21 y ALK).
Fig. 1.Placas eritematosas infiltradas en la región lumbosacra.
Fig. 2.Célula de Reed-Sternberg (flecha continua) y célula de Hodgkin (flecha discontinua). (Hematoxilina-eosina, ×100.)
Fig. 3.Infiltrado inflamatorio acompañante con linfocitos, histiocitos y eosinófilos. (Hematoxilina-eosina, ×20.)
DISCUSIÓN
La enfermedad de Hodgkin puede afectar a la piel entre el 13 y el 53 % de los pacientes. La mayoría lo hace de forma inespecífica, en forma de numerosas afecciones, entre las que destacan la hiperpigmentación, el prurito, la ictiosis, urticaria, eritrodermia, dermatitis exfoliativa, eritema multiforme, eritema nudoso, erupciones psoriasiformes y herpes zóster1-3 . La afectación cutánea específica por enfermedad de Hodgkin es mucho menos frecuente, y aparece, según distintas series, entre el 0,5 y el 7,5 % de los pacientes6 . Las series más recientemente publicadas hablan de frecuencias más cercanas al 0,5 que al 7,5 %, lo que se podría explicar por los avances en el diagnóstico precoz y los mejores tratamientos3,7 . Esta afectación específica puede producirse por tres vías distintas. La forma más frecuente de extensión suele ser por flujo linfático retrógrado, desde grupos ganglionares afectados por la enfermedad8 . La segunda forma consiste en la extensión directa desde los ganglios linfáticos o partes blandas invadidos previamente por la enfermedad. La forma menos frecuente se produce mediante diseminación hematógena3,6 .
Entre los tipos de lesiones que se han descrito se pueden encontrar pápulas, nódulos y placas infiltradas, lesiones ulceradas, eritrodermia e, incluso, la combinación de varias de estas formas4 . Estas lesiones pueden ir acompañadas o precedidas de prurito9 . Desde el punto de vista de la dermatopatología, el diagnóstico de enfermedad de Hodgkin de la piel es difícil y siempre hay que tener en cuenta el contexto del paciente. La histopatología de la enfermedad de Hodgkin tipo depleción linfocitaria en la piel se caracteriza por la presencia de grandes células anaplásicas mononucleadas, que se denominan células de Hodgkin, o multinucleadas, las llamadas células de Reed-Sternberg. Estas células se acompañan de un escaso cortejo de células inflamatorias no neoplásicas, entre las que se incluyen linfocitos, eosinófilos, neutrófilos, histiocitos y células plasmáticas. La presencia de escasos linfocitos en este infiltrado es propia del tipo depleción linfocitaria de la enfermedad de Hodgkin, como ocurre con su equivalente ganglionar. Las células de Reed-Sternberg son muy características en esta enfermedad10 , pero la presencia de dichas células en un infiltrado cutáneo no es tan específica, ya que se pueden observar en otros procesos como la papulosis linfomatoide y el linfoma cutáneo anaplásico de células grandes, entre otros11 . El diagnóstico diferencial debe realizarse, en primer lugar, con los linfomas cutáneos primarios, como las enfermedades linfoproliferativas primarias cutáneas CD30 positivas de células T (linfoma cutáneo primario anaplásico de células grandes, papulosis linfomatoide y lesiones limítrofes), donde se observa inmunorreacción frente a CD30 y CD4 (y es posible que para algún otro marcador T como CD3, CD8 y CD43). También con el linfoma anaplásico de células grandes que es positivo para CD30 y ALK y con el linfoma difuso de células grandes B que muestra inmunopositividad para marcadores B como CD20 y CD79a. También se plantea el diagnóstico diferencial con neoplasias no linfoides como metástasis cutánea por melanoma, que suelen ser HMB 45 positivas, metástasis cutáneas por carcinomas pobremente diferenciados (suelen ser positivas para citoqueratinas) o por infiltración cutánea por lesiones fibrohistiocitarias (CD68 positivas). Los hallazgos inmunohistoquímicos característicos de la enfermedad de Hodgkin son los que muestran la positividad para CD15 y CD30 y negatividad para CD45 propios de la célula de Reed-Sternberg11 .
La mayoría de autores coinciden en destacar que la afectación cutánea específica por enfermedad de Hodgkin ocurre en estadios tardíos de la enfermedad y suponen un empeoramiento del pronóstico 11,12 .
Correspondencia:
Carlos Serra-Guillén. Servicio de Dermatología. Instituto Valenciano de Oncología. Profesor Beltrán Báguena, 8. 46009 Valencia. España. cserraguillen@hotmail.com
Recibido el 11 de mayo de 2004. Aceptado el 21 de julio de 2004.